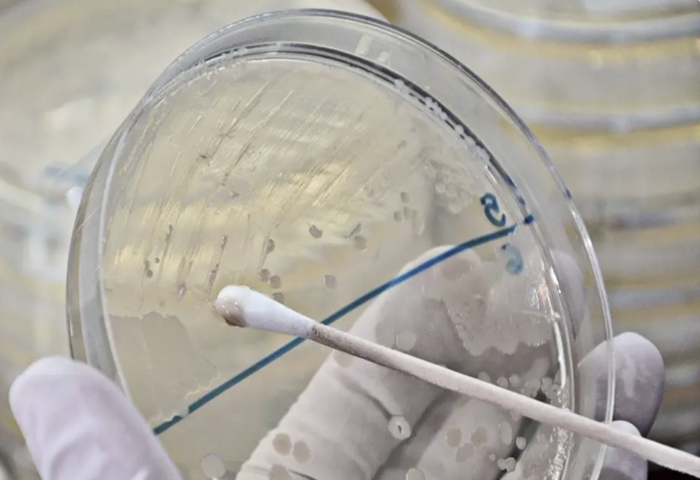

(台泰時報10月31日電)泰國食品藥物管理局(FDA)公布,2025年度共抽驗54款鼻通,其中39款產品檢出微生物含量超出標準,占比近七成。衛生部呼籲民眾立即停止使用問題批號產品,並建議僅購買來源可追溯、標示清楚的合法商品。
FDA秘書長蘇帕塔拉(Supatra Boonseum)指出,檢測行動起因於今年5月網路上流傳有關鼻通含霉菌、恐損害肺部健康的報導,當局遂聯合醫學科學部展開隨機抽樣,涵蓋多個品牌與生產地點。檢驗結果顯示,多款樣品存在細菌、酵母菌與黴菌污染,部分更檢出具致病性的厭氧桿菌。
其中「鴻泰牌鼻通二號配方」(製造批號000332,生產日期2024年12月9日)及「CHMA Herb鼻通」(批號NF2522503001,生產日期2025年3月3日)被確認含有梭狀芽孢桿菌屬(Clostridium spp.)超標,其中一例為可致病的產氣莢膜梭菌(Clostridium perfringens)。當局已要求業者召回受影響批次,其餘批次產品仍可正常銷售使用。
蘇帕塔拉提醒消費者,應立即核對產品批號,若屬通報批次應停止使用並聯絡廠商退貨。她並強調:「請勿恐慌,但務必提高警覺,購買前應檢查包裝資訊與許可編號,避免使用來源不明或無標示產品。」
衛生部同時提供三項安全建議:
一、購買時須選擇可信賣場,確認標籤含生產者名稱、產品登記編號、製造與有效日期,可掃描FDA QR Code查驗資訊;
二、使用後應緊閉瓶蓋,置於乾燥陰涼處,避免潮濕與手指接觸內部藥材,以防再污染;
三、鼻通若為包布藥材型,其保存期短於液體或膏狀產品,使用前若發現氣味或顏色異常應立即棄置。
醫學科學部局長沙拉武(Sarawut Boonsuk)進一步說明,該機構以「平皿培養法(Plate Count)」測定空氣中微生物與黴菌數量,並以染色法確認特定致病菌。檢測標準規定:可生長於空氣中的微生物不得超過200菌落/克,酵母菌與黴菌總數不得超過20菌落/克,且不得檢出金黃色葡萄球菌、綠膿桿菌及梭狀芽孢桿菌。
他指出,今次抽驗發現多數不合格樣品皆在空氣性微生物與黴菌數超標,其中部分樣品檢出產氣莢膜梭菌,該菌常見於土壤中,能在無氧環境繁殖。若吸入污染產品,免疫力低下者可能出現呼吸困難、喉嚨疼痛、咳嗽或痰液帶血等症狀。
沙拉武表示,為防止類似事件再發,建議製造商在草本原料製程中應採取清洗、烘乾或輻射滅菌等步驟,以減少微生物含量。醫學科學部亦願協助中小型業者在產品登錄前進行品質檢測,確保草本產品安全上市,維護消費者健康。
圖片來源:Bangkok Biz News 圖片日期:2025年10月30日
